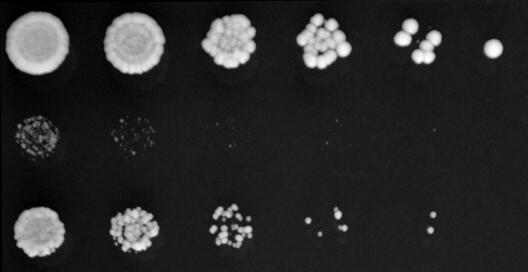

Stau in der Proteinfabrik

Die Herstellung von Proteinen in Zellen ist ein absolut essentieller Prozess: Treten in der Proteinfabrik Schwierigkeiten auf, wirkt sich das stark auf den Organismus aus – Krankheiten sind häufig die Folge. Max-Planck-Forschungsgruppenleiter Dr. Sebastian Leidel und seine Mitarbeiterin Dr. Danny Nedialkova haben nun erstmals in lebenden Zellen gezeigt, dass eine winzige fehlende Modifikation an Transfer-RNA (tRNA) die Proteinherstellung verlangsamt und zu Stau in der Proteinfabrik führt. Die Folge: Proteinketten werden falsch zusammengefaltet. Proteinaggregate, wie wir sie von Alzheimer und Parkinson kennen, sind die Folge. Die Zellen versuchen zwar den Schaden zu reparieren; dies gelingt aber nicht immer und die Zelle kollabiert. Diese nun in der renommierten Fachzeitschrift Cell veröffentlichte Studie liefert damit die erste direkte Erklärung, wie kleinste, fehlerhafte oder fehlende Modifikationen an tRNA neurodegenerative Erkrankungen hervorrufen können.
Die Forschungsgruppe von Dr. Sebastian Leidel ist die einzige, die am Max-Planck-Institut für molekulare Biomedizin in Münster an Hefe forscht. Auch sein Forschungsthema RNA ist eher ungewöhnlich. Doch ist die vorliegende Arbeit für sehr viele Wissenschaftler interessant. „Wir beschäftigen uns mit den grundlegendsten Bausteinen des Lebens und haben als erste Gruppe anhand von lebenden Zellen gezeigt, dass die Übersetzungsgeschwindigkeit der genetischen Information die Aktivität der Proteine beeinflusst,“ sagt Dr. Sebastian Leidel. „Und – was vielleicht noch wichtiger ist: Die Ergebnisse meiner Mitarbeiterin Frau Dr. Danny Nedialkova können erklären, wie bestimmte neurodegenerativen Erkrankungen entstehen.“
Der Hefepilz eignet sich hervorragend, um die Proteinherstellung zu untersuchen. Die Ergebnisse solcher Studien können gut auf menschliche Zellen übertragen werden. Denn die Hefezellen sind denen des Menschen sehr ähnlich: Beide besitzen einen Zellkern mit dem Erbgut, haben Mitochondrien, die die Zellen mit Energie versorgen, und verfügen über Ribosomen – die Proteinfabriken der Zellen. Eine Schlüsselfunktion in diesen Fabriken haben die Übersetzer-Moleküle – die ca. 40 verschiedenen tRNA-Moleküle.

Sollen Gene abgelesen werden, werden Kopien der Erbinformation – die sogenannte mRNA Stränge – erstellt. Während Ribosomen die mRNA lesen, flitzen die passenden tRNA-Moleküle durch die Ribosomen und verlängern die Proteinkette um jeweils eine Aminosäure. Dies geschieht mit einer Geschwindigkeit von ungefähr 10 tRNAs pro Sekunde.
Damit die Proteinfabrik wie geschmiert läuft, werden tRNA-Moleküle chemisch getunt. Defekte an solchen Modifikationen - manchmal ein einziges Atom - können zu neurodegenerative Erkrankungen führen. „Aber wie genau kann eine so kleine Modifikation solche gravierende Auswirkungen haben?“ fragte sich Leidel.
Seine Mitarbeiterin Dr. Danny Nedialkova schaute sich die Ablese- und Übersetzungsgeschwindigkeit in Hefezellen und Nematoden an. Sie isolierte die durch Ribosomen besetzten, also aktiv abgelesenen mRNA-Stränge. Mit der ‚Ribosomen Profiling’ Methode analysierte sie Hefezellen mit intakten tRNAs und solche, bei denen eine einzige Modifikation am tRNA-Molekül fehlte.
„Durch diese hochmoderne Technik konnten wir Millionen Moleküle gleichzeitig quantitativ untersuchen“, sagt Nedialkova. „So konnten wir klar nachweisen, dass Ribosomen in Zellen mit defekten tRNA länger brauchen, um bestimmte Wörter des genetischen Codes zu lesen.“
Aber was passiert, wenn es zum Stau in der Proteinfabrik kommt? Die Antwort suchten die Forscher unter allen Genen, die in den Zellen abgelesen werden. „Wir wollten wissen, welche Proteine die Zellen vermehrt benötigen. Deshalb haben wir die Zellen quasi selber gefragt, wie es ihnen geht“, sagt Nedialkova.
Zu ihrer Überraschung entdeckten Leidel und Nedialkova, dass Zellen mit fehlerhaften tRNA-Molekülen mehr Proteine herstellen, die defekte Proteine reparieren. „Zudem fanden wir Protein-Aggregate in den Zellen, ein Phänomen, das man von Alzheimer und Parkinson kennt“, sagt Nedialkova. Das Beseitigen von falsch gefalteten Proteinen kostet die Zellen viel Kraft und Energie. „Das Gleichgewicht in den Zellen kippt und als Folge können die Zellen die Lage nicht mehr meistern – sie sterben“, sagt Nedialkova.
Der Fehler liegt also im Detail, hat aber immense Auswirkungen. Leidel: „Wenn dem tRNA-Molekül nur eine einzige chemische Gruppe fehlt, stockt die Proteinfabrik an unzählig vielen Stellen der mRNA. Es entstehen massive Proteinaggregate, die die Zellen nicht mehr beseitigen können.“ Besonders Nervenzellen reagieren sehr empfindlich auf solche Proteinaggregate. „Unsere Ergebnisse eröffnen daher ganz neue Perspektiven für die Erforschung und Behandlung von neurodegenerativen Erkrankungen“, sagt Leidel.
Dr. Sebastian Leidel ist Max-Planck-Forschungsgruppenleiter und erhielt 2012 einen ERC Starting Grant des Europäischen Forschungsrates. Die vorliegende Veröffentlichung ist Ergebnis dieser Förderung. Leidel ist Mitglied im Exzellenzcluster ‚Cells in Motion’. Seine Mitarbeiterin Dr. Danny Nedialkova wurde unter anderem von der European Molecular Biology Organization (EMBO) gefördert.